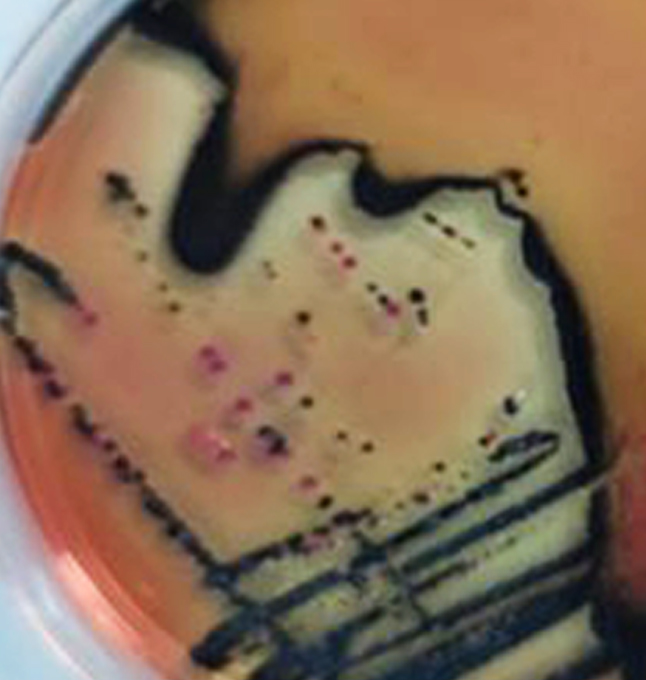
Catherine Soft

What you get
Minimal Design
Nam feugiat a ante sollicitudin luctus. Quisque eget placerat massa. Ut quis ligula ornare, pellentesque velit eget, vestibulum est. Donec pretium tristique elit eget sodales. Pellentesque posuere.
Easy to use
Aliquam massa massa, consectetur non mattis fringilla, sodales ac turpis. Morbi ac felis sagittis, faucibus mauris vitae, placerat mauris.
Compatible Browsers
Nam maximus elit a metus luctus, a faucibus magna mattis. Ut malesuada viverra iaculis. Nunc euismod sit amet neque a tincidunt.
User Friendly
Maecenas maximus velit lorem, quis pharetra turpis fringilla id. Vestibulum tempor facilisis efficitur. Sed nec nisi sit amet nibh pellentesque elementum.
HTML5 & CSS3
In viverra ipsum ornare sapien rhoncus ullamcorper. Vivamus vitae risus ac mi vehicula sagittis. Nulla dictum magna sit amet pharetra aliquam.
Quick Support
Mauris rutrum est at fringilla pulvinar. Nam ligula urna, lobortis non scelerisque vel, molestie eu massa. Nullam mattis elit at tortor accumsan.
Managed Stuffs
Quisque ullamcorper sem quis sapien cursus efficitur. Sed id sodales ipsum. Morbi eleifend tempus erat sit amet vehicula. Nulla at posuere tellus, non mattis erat. Nulla id massa gravida.